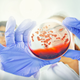

Podrobnejša raziskava vira okužbe z norovirusom pokazala, da je bila kriva embalaža v kateri so prodajali biftek. v Ilirski Bistrici je konec preteklega leta izbruhnila okužba z norovirusom. Po poročanju …
Maribor24 · 3L

Po izbruhu okužbe z norovirusom v Ilirski Bistrici konec preteklega leta so pristojne zdravstvene inštitucije zdaj izdale poročilo preiskave. Ta je pokazala, da vir okužb niso bila živila, temveč da …
24ur · 3L

Preiskava izbruha norovirusa v Ilirski Bistrici je pokazala, da vir okužb, ki so povzročile zdravstvene težav več ljudem, niso bila živila iz tamkajšnje mesnice. Nacionalni inštitut za javno zdravje (NIJZ) …
Žurnal24 · 3L
Preiskava izbruha norovirusa v Ilirski Bistrici je pokazala, da vir okužb, ki so povzročile zdravstvene težav več ljudem, niso bila živila iz tamkajšnje mesnice. Kot so sporočili z Nacionalnega inštituta …
Regional · 3L

Preiskava izbruha norovirusa v Ilirski Bistrici je pokazala, da vir okužb, ki so povzročile zdravstvene težav več ljudem, niso bila živila iz tamkajšnje mesnice. Kot so sporočili z Nacionalnega inštituta …
Politikis · 3L

Preiskava izbruha norovirusa v Ilirski Bistrici je pokazala, da vir okužb, ki so povzročile zdravstvene težav več ljudem, niso bila živila iz tamkajšnje mesnice. . Nacionalni urad za javno zdravje …
Svet24 · 3L

Približno 70 ljudi iz Ilirske Bistrice je po prvotnih informacijah konec decembra poiskalo zdravniško pomoč, ena oseba je bila hospitalizirana. Zdaj je znano, kaj je vzrok okužbe.
Mariborinfo · 3L

Preiskava izbruha norovirusa v Ilirski Bistrici je pokazala, da vir okužb, ki so povzročile zdravstvene težav več ljudem, niso bila živila iz tamkajšnje mesnice. Kot so sporočili z Nacionalnega inštituta …
Metropolitan.si · 3L

Preiskava izbruha norovirusa v Ilirski Bistrici je pokazala, da vir okužb, ki so povzročile zdravstvene težave več ljudem, niso bila živila iz tamkajšnje mesnice. Kot so sporočili z Nacionalnega inštituta …
Primorske novice · 3L
notranjskapivkasežanapostojnasrednjakrasbrkinisrednja primorskailirska bistricanoviceprimorska
Preiskava izbruha norovirusa v Ilirski Bistrici je pokazala, da vir okužb, ki so povzročile zdravstvene težav več ljudem, niso bila živila iz tamkajšnje mesnice. Kot so sporočili z Nacionalnega inštituta …
Hudo.com · 3L
Fotografija je simbolična (Foto: iStock) Preiskava izbruha norovirusa v Ilirski Bistrici je pokazala, da vir okužb, ki so povzročile zdravstvene težav več ljudem, niso bila živila iz tamkajšnje mesnice. Kot …
Nova24TV · 3L

Preiskava izbruha norovirusa v Ilirski Bistrici je pokazala, da vir okužb, ki so povzročile zdravstvene težav več ljudem, niso bila živila iz tamkajšnje mesnice. Kot so sporočili z Nacionalnega inštituta …
Slovenske novice · 3L
noravirusdriskanijzslovenska bistricatatarski biftekbruhanje

Preiskava izbruha norovirusa v Ilirski Bistrici je pokazala, da vir okužb, ki so povzročile zdravstvene težav več ljudem, niso bila živila iz tamkajšnje mesnice. Kot so sporočili z Nacionalnega inštituta …
Siol.net · 3L

Preiskava izbruha norovirusa v Ilirski Bistrici je pokazala, da vir okužb, ki so povzročile zdravstvene težav več ljudem, niso bila živila iz tamkajšnje mesnice. Kot so sporočili z Nacionalnega inštituta …
Reporter · 3L

NIJZ je skupaj z upravo za varno hrano, veterinarstvo in varstvo rastlin ter Nacionalnim laboratorijem za zdravje, okolje in hrano zaključil preiskavo izbruha nalezljive bolezni v Ilirski Bistrici. Glede na …
Večer · 3L

NIJZ je skupaj z upravo za varno hrano in nacionalnim laboratorijem (NLZOH) sklenil preiskavo izbruha nalezljive bolezni v Ilirski Bistrici, ki je pokazala, da vir okužb niso bila živila, temveč …
RTV Slovenija · 3L
Nacionalni inštitut za javno zdravje (NIJZ) je skupaj z Upravo za varno hrano, veterinarstvo in varstvo rastlin (UVHVVR) in Nacionalnim laboratorijem za zrak, okolje in hrano (NLZOH) zaključil preiskavo izbruha …
Dnevnik · 3L